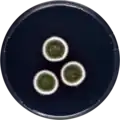
Aspergillus creber growing on CYA plate

Aspergillus creber
| Aspergillus creber | |
|---|---|
| Scientific classification | |
| Kingdom: | Fungi |
| Division: | Ascomycota |
| Class: | Eurotiomycetes |
| Order: | Eurotiales |
| Family: | Aspergillaceae |
| Genus: | Aspergillus |
| Species: | A. creber
|
| Binomial name | |
| Aspergillus creber Jurjevic, Peterson & Horn (2012)[1]
| |
Aspergillus creber is a species of fungus in the genus Aspergillus.[1] It is from the Versicolores section.[1][2] The species was first described in 2012.[1]
Growth and morphology
A. creber has been cultivated on both Czapek yeast extract agar (CYA) plates and Malt Extract Agar Oxoid® (MEAOX) plates. The growth morphology of the colonies can be seen in the pictures below.
-
Aspergillus creber growing on CYA plate
Aspergillus creber growing on CYA plate -
 Aspergillus creber growing on MEAOX plate
Aspergillus creber growing on MEAOX plate
References
- ^ a b c d Jurjevic, Zeljko; Peterson, Stephen W.; Horn, Bruce W. (2012). "Aspergillus section Versicolores: nine new species and multilocus dNA sequence based phylogeny". IMA Fungus. 3 (1): 59–795. doi:10.5598/imafungus.2012.03.01.07. ISSN 2210-6340. PMC 3399103. PMID 23155501.
- ^ Siqueira, J.P.Z.; Sutton, D.A.; Garcia, D.; Gené, J.; Thomson, P.; Wiederhold, N.; Guarro, J. (2016). "Species diversity of Aspergillus section Versicolores in clinical samples and antifungal susceptibility". Fungal Biology. 120 (11): 1458–1467. doi:10.1016/j.funbio.2016.02.006. PMID 27742099.
Further reading
- Micheluz A, Manente S, Tigini V, Prigione V, Pinzari F, Ravagnan G, Varese GC (2015). "The extreme environment of a library: xerophilic fungi inhabiting indoor niches". International Biodeterioration & Biodegradation. 99: 1–7. doi:10.1016/j.ibiod.2014.12.012. hdl:10278/3638529. S2CID 53466387.
- Micheluz A, Sulyok M, Manente S, Krska R, Varese GC, Ravagnan G (2016). "Fungal secondary metabolite analysis applied to Cultural Heritage: the case of a contaminated library in Venice". World Mycotoxin Journal. 9 (3): 397–407. doi:10.3920/WMJ2015.1958. hdl:2318/1562648. S2CID 87667921.